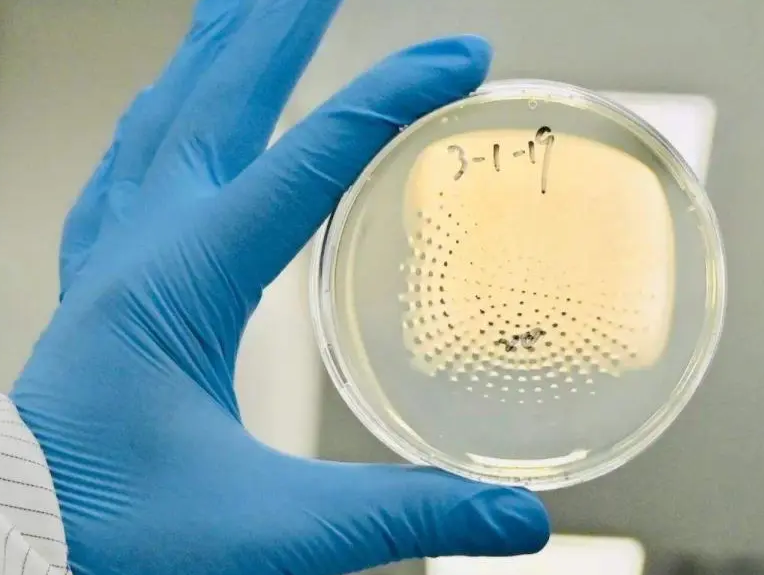
上海環境檢測咨詢服務有限公司 上海環境檢測咨詢服務有限公司

潔凈室沉降菌測試檢測(空氣沉降菌菌落數測試)
上海專業潔凈室檢測技術公司是合格的第三方潔凈室檢測機構(咨詢電話:021-56572786,13816130886 王先生)普遍要求要有全面的潔凈相關檢測能力,可為藥品GMP車間、電子無塵車間、食品藥品包裝材料車間、無菌醫療器械車間、醫院潔凈手術室、生物普遍實驗室、保健食品GMP車間、化妝品/消車間、動物實驗室、獸藥GMP車間、飲用桶裝水車間等潔凈室、潔凈廠房提供第三方檢測、調試、咨詢等專業技術服
- 型號:
上海專業潔凈室檢測技術公司是合格的第三方潔凈室檢測機構(咨詢電話:021-56572786,13816130886 王先生)普遍要求要有全面的潔凈相關檢測能力,可為藥品GMP車間、電子無塵車間、食品藥品包裝材料車間、無菌醫療器械車間、醫院潔凈手術室、生物普遍實驗室、保健食品GMP車間、化妝品/消車間、動物實驗室、獸藥GMP車間、飲用桶裝水車間等潔凈室、潔凈廠房提供第三方檢測、調試、咨詢等專業技術服
上海專業潔凈室檢測技術公司是合格的第三方潔凈室檢測機構(咨詢電話:021-56572786,13816130886 王先生)普遍要求要有全面的潔凈相關檢測能力,可為藥品GMP車間、電子無塵車間、食品藥品包裝材料車間、無菌醫療器械車間、醫院潔凈手術室、生物普遍實驗室、保健食品GMP車間、化妝品/消車間、動物實驗室、獸藥GMP車間、飲用桶裝水車間等潔凈室、潔凈廠房提供第三方檢測、調試、咨詢等專業技術服務。
一、測試說明
空氣沉降菌菌落數測試的目的是確認潔凈室空氣中懸浮微生物是否滿足標準值。
二、測試儀器:
成品培養基
型號:φ90mm
附有儀器校準證書,且在校準時間有效期內。
三、測試程序:
(1)此項測試應在潔凈室測試項目之后進行,檢測前應對器皿進行消毒滅菌,測試過程中應對培養皿或培養基條做陰性對照。
(2)宜采用φ90培養皿進行采樣,培養皿放在具有代表性的地點和氣流擾動極小的地方。當用戶無特定要求時,培養皿應布置在地面及其以上0.8m之內的任意高度。
(3)每一間潔凈室或每一控制區域應設一個陰性對照。
(4)采樣點數應不少于房間懸浮粒子測試的測點數。
(5)培養皿應從內向外布置,從外向內收皿,沉降時間不宜超過1h,每布完一個皿,皿蓋只允許斜放在皿邊上,對照皿蓋挪開即蓋上。
(6)布皿前和收皿后,均應用雙層包裝保護培養皿,以防污染。
(7)收皿后,皿應倒置擺放,并應及時放入培養箱中培養,在培養箱外時間不宜超過2h。
四、收費方式:
根據測試點位數量。

